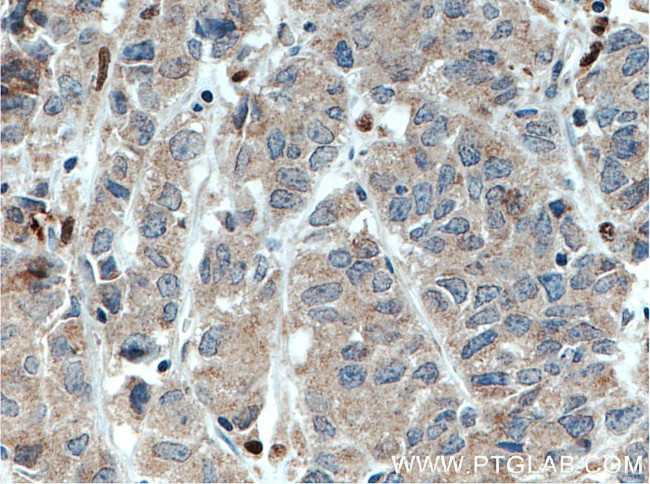
DNAJB9 Antibody in Immunohistochemistry (Paraffin) (IHC (P))

Search
Proteintech
DNAJB9 Polyclonal Antibody
{{$productOrderCtrl.translations['antibody.pdp.commerceCard.promotion.promotions']}}
{{$productOrderCtrl.translations['antibody.pdp.commerceCard.promotion.viewpromo']}}
{{$productOrderCtrl.translations['antibody.pdp.commerceCard.promotion.promocode']}}: {{promo.promoCode}} {{promo.promoTitle}} {{promo.promoDescription}}. {{$productOrderCtrl.translations['antibody.pdp.commerceCard.promotion.learnmore']}}
产品信息
13157-1-AP
种属反应
已发表种属
宿主/亚型
分类
类型
抗原
偶联物
形式
浓度
规格
纯化类型
保存液
内含物
保存条件
运输条件
产品详细信息
Immunogen sequence: SYYDILGVP KSASERQIKK AFHKLAMKYH PDKNKSPDAE AKFREIAEAY ETLSDANRRK EYDTLGHSAF TSGKGQRGSG SSFEQSFNFN FDDLFKDFGF FGQNQNTGSK KRFENHFQTR QDGGSSRQRH HFQEFSFGGG LFDDMFEDME KMFSFSGFDS TNQHTVQTEN RFHGSSKHCR TVTQRRGNMV TTYTDCSGQ (26-223 aa encoded by BC028912)
靶标信息
This gene is a member of the J protein family. J proteins function in many cellular processes by regulating the ATPase activity of 70 kDa heat shock proteins. This gene is a member of the type 2 subgroup of DnaJ proteins. The encoded protein is localized to the endoplasmic reticulum. This protein is induced by endoplasmic reticulum stress and plays a role in protecting stressed cells from apoptosis.
仅用于科研。不用于诊断过程。未经明确授权不得转售。
生物信息学
蛋白别名: DKFZP564F1862; DNA j protein b9; DnaJ (Hsp40) homolog, subfamily B, member 9; DnaJ homolog subfamily B member 9; DNAJB9; Endoplasmic reticulum DNA J domain-containing protein 4; endoplasmic reticulum DnaJ homolog 4; ER-resident protein ERdj4; Mdg-1; MDG1; mDj7; microvascular endothelial differentiation gene 1; Microvascular endothelial differentiation gene 1 protein; unnamed protein product
基因别名: AA408011; AA673251; AA673481; AW556981; DNAJB9; ERdj4; MDG-1; MDG1; mDj7; MST049; MSTP049; UNQ743/PRO1471
UniProt ID: (Human) Q9UBS3, (Mouse) Q9QYI6
Entrez Gene ID: (Human) 4189, (Mouse) 27362